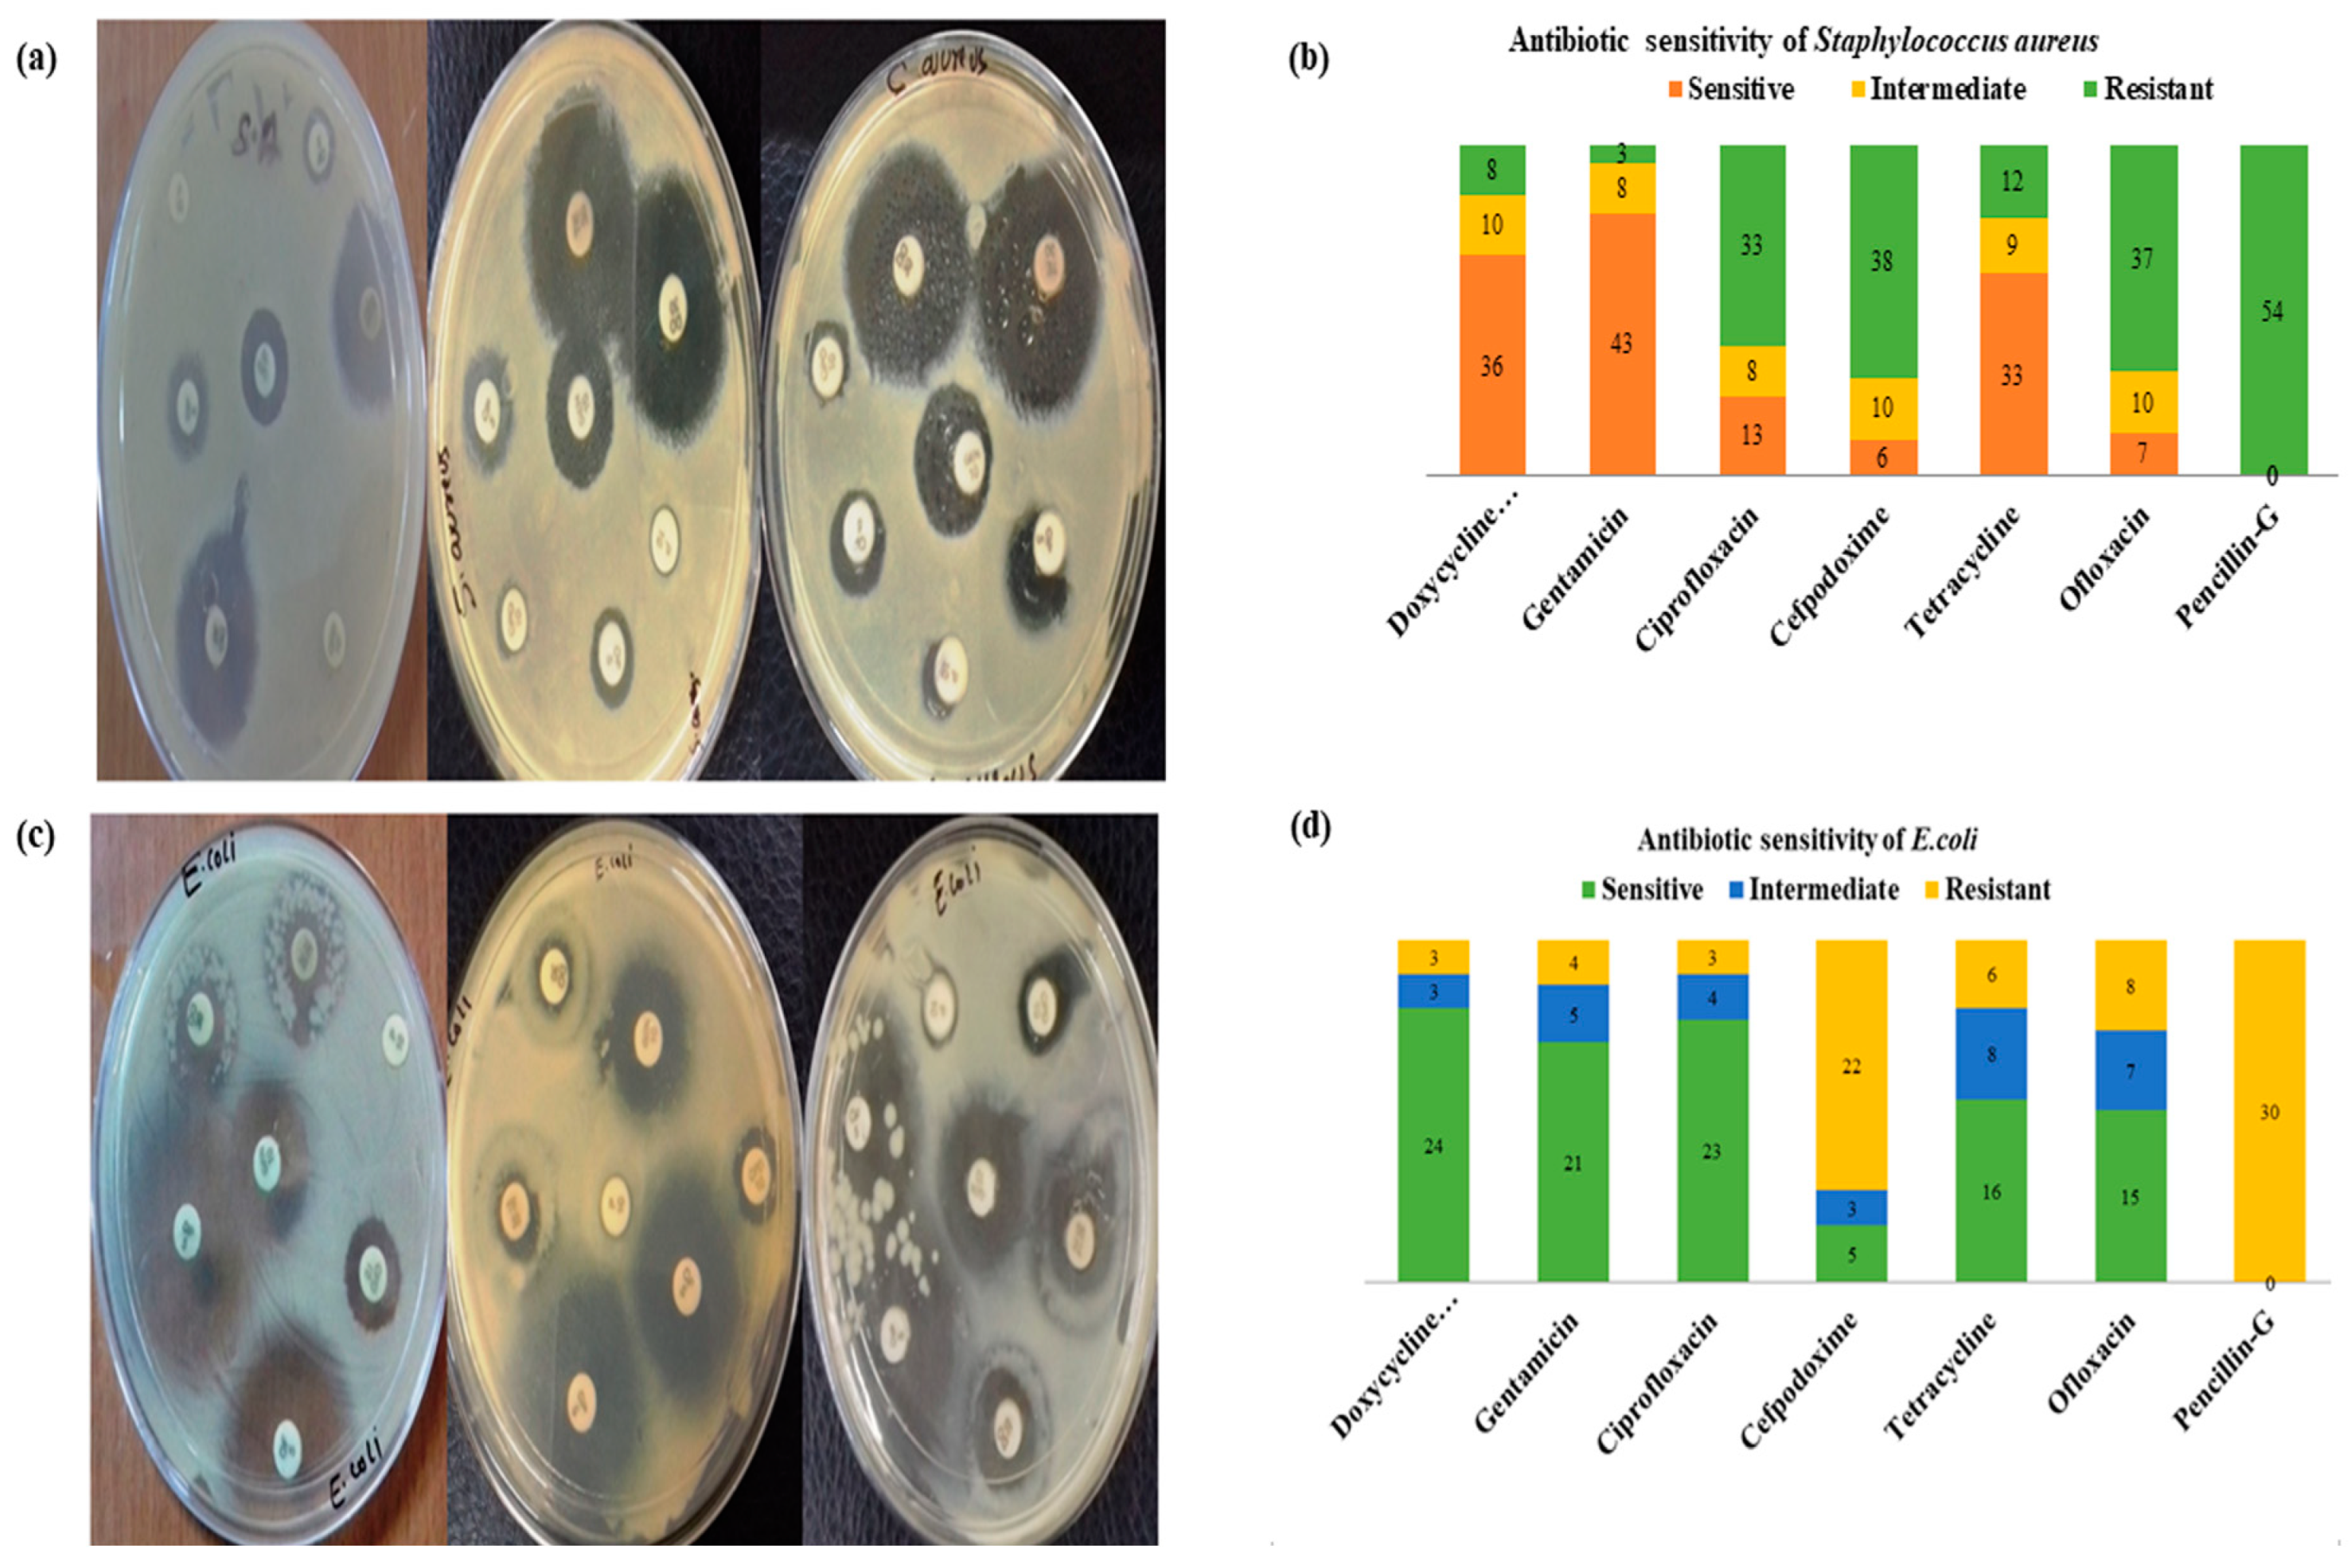
Molecules 27 08631 g006 Molecules 27 08631 g006

Milk-Compositional Study of Metabolites and Pathogens in the Milk of Bovine Animals Affected with Subclinical Mastitis
Abstract
1. Introduction
2. Results and Discussion
2.1. GC-MS Analysis
2.2. Metabolomic Data Analysis
2.2.1. MetaboAnalyst
2.2.2. Compound Mapping
2.2.3. Pathway Analysis
2.2.4. Metabolite Set Enrichment Analysis
2.3. Milk Chemistry
2.3.1. Electrical Conductivity (EC) and pH
2.3.2. Milk Fat and Protein
2.3.3. Lactose and SNF
2.3.4. Density
2.4. Principal Component Analysis
2.5. Pathogen Identification
2.5.1. Isolation of Staphylococcus aureus
2.5.2. Isolation of E. coli
2.6. In Vitro Antibiotic Sensitivity Test
3. Materials and Methods
3.1. Study Area
3.2. Study Design
3.3. Screening Tests
3.3.1. California Mastitis Test (CMT)
3.3.2. pH
3.3.3. Electrical Conductivity (EC)
3.3.4. Somatic Cell Count (SCC)
3.4. Sample Collection
3.5. Gas Chromatography–Mass Spectrometry (GC-MS) Analysis
3.6. Metabolic Pathway Analysis
3.7. Metabolite Identification
3.8. Analysis of Chemical Properties of Milk
3.9. Isolation and Identification of Causative Agents
3.10. Antibiogram
3.11. Preparation of Inoculums
3.12. Antimicrobial Susceptibility Test (AST)
3.13. Statistical Analysis
4. Conclusions
Author Contributions
Funding
Institutional Review Board Statement
Informed Consent Statement
Data Availability Statement
Acknowledgments
Conflicts of Interest
References
- Levison, L.J.; Miller-Cushon, E.K.; Tucker, A.L.; Bergeron, R.; Leslie, K.E.; Barkema, H.W.; DeVries, T.J. Incidence rate of pathogen-specific clinical mastitis on conventional and organic Canadian dairy farms. J. Dairy Sci. 2016, 99, 1341–1350. [Google Scholar] [CrossRef]
- Vakkamaki, J.; Taponen, S.; Heikkila, A.M.; Pyorala, S. Bacteriological etiology and treatment of mastitis in Finnish dairy herds. Acta Vet. Scand. 2017, 59, 33. [Google Scholar] [CrossRef] [PubMed]
- Ali, A.; Maqbool, I.; Ayaz, A.; Mir, M.R.; Ganie, S.A. Ability of Diagnostic Tests to Predict Subclinical Mastitis and Intramammary Infections in Quarters from Lactating Dairy Cows. Res. J. Agril. Sci. 2021, 12, 1982–1986. [Google Scholar]
- Ali, A.; Mir, B.A.; Bhat, R.R.; Baba, O.K.; Hussain, S.A.; Rashid, S.M. Metabolic profiling of dairy cows affected with subclinical and clinical mastitis. J. Entomol. Zool. Stud. 2017, 5, 1026–1028. [Google Scholar]
- Fox, P.F. Milk: An overview. In Milk Proteins—From Expression to Food; Thompson, A., Boland, M., Singh, H., Eds.; Academic Press: New York, NY, USA, 2009; pp. 1–53. [Google Scholar]
- Addis, M.F.; Tanca, A.; Uzzau, S.; Oikonomou, G.; Bicalho, R.C.; Moroni, P. The bovine milk microbiota: Insights and perspectives from-omics studies. Mol. Biosyst. 2016, 12, 2359–2372. [Google Scholar] [CrossRef]
- Bhatt, V.D.; Ahir, V.B.; Koringa, P.G.; Jakhesara, S.J.; Rank, D.N.; Nauriyal, D.S.; Joshi, C.G. Milk microbiome signatures of subclinical mastitis-affected cattle analysed by shotgun sequencing. J. Appl. Microbiol. 2012, 112, 639–650. [Google Scholar] [CrossRef]
- Kuehn, J.S.; Gorden, P.J.; Munro, D.; Rong, R.; Dong, Q.; Plummer, P.J.; Phillips, G.J. Bacterial community profiling of milk samples as a means to understand culture-negative bovine clinical mastitis. PLoS ONE 2013, 8, e61959. [Google Scholar] [CrossRef]
- Oikonomou, G.; Bicalho, M.L.; Meira, E.; Rossi, R.E.; Foditsch, C.; Machado, V.S.; Bicalho, R.C. Microbiota of cow’s milk; distinguishing healthy, sub-clinically and clinically diseased quarters. PLoS ONE 2014, 9, e85904. [Google Scholar] [CrossRef]
- Ganda, E.K.; Bisinotto, R.S.; Lima, S.F.; Kronauer, K.; Decter, D.H.; Oikonomou, G.; Bicalho, R.C. Longitudinal metagenomic profiling of bovine milk to assess the impact of intramammary treatment using a third-generation cephalosporin. Sci. Rep. 2016, 6, 37565. [Google Scholar] [CrossRef]
- Akram, N.; Chaudhary, A.H.; Ahmed, S.; Ghuman, M.A.; Nawaz, G.; Hussain, S. Isolation of bacteria from mastitis affected bovine milk and their antibiogram. Eur. J. Vet. Med. 2013, 2, 38–46. [Google Scholar]
- Jeykumar, M.; Vinodkumar, G.; Bashir, B.P.; Sudhakar, K. Antibiogram of mastitis pathogens in the milk of crossbred cows in Namakkal district, Tamil Nadu. Vet. World. 2013, 6, 354–356. [Google Scholar] [CrossRef]
- Dufour, S.; Labrie, J.; Jacques, M. The Mastitis Pathogens Culture Collection. Microbiol. Resour. Announc. 2019, 8, e00133-19. [Google Scholar] [CrossRef] [PubMed]
- Manrique, L.E.T.; Villate-Hernández, J.R.; Andrade-Becerra, R.J. Bacterial and fungal infectious etiology causing mastitis in dairy cows in the highlands of Boyacá (Colombia). Rev. Fac. Med. Vet.-Zootec. 2019, 66, 208–218. [Google Scholar] [CrossRef]
- Boudonck, K.J.; Mitchell, M.W.; Nemet, L.; Keresztes, L.; Nyska, A.; Shinar, D.; Rosenstock, M. Discovery of metabolomics biomarkers for early detection of nephrotoxicity. Toxicol. Pathol. 2009, 37, 280–292. [Google Scholar] [CrossRef] [PubMed]
- Mansor, R. Proteomic and Metabolomic Studies on Milk during Bovine Mastitis. Ph.D. Thesis, University of Glasgow, Glasgow, Scotland, UK, 2012. [Google Scholar]
- Hunt, K.M.; Williams, J.E.; Shafii, B.; Hunt, M.K.; Behre, R.; Ting, R.; McGuire, M.A. Mastitis is associated with increased free fatty acids, somatic cell count, and interleukin-8 concentrations in human milk. Breastfeed Med. 2013, 8, 105–110. [Google Scholar] [CrossRef] [PubMed]
- German, J.B.; Dillard, C.J. Composition, structure and absorption of milk lipids: A source of energy, fat-soluble nutrients and bioactive molecules. Crit. Rev. Food Sci. Nutr. 2006, 46, 57–92. [Google Scholar] [CrossRef] [PubMed]
- Coppa, M.; Ferlay, A.; Leroux, C.; Jestin, M.; Chilliard, Y.; Martin, B.; Andueza, D. Prediction of milk fatty acid composition by near infrared reflectance spectroscopy. Int. Dairy J. 2010, 20, 182–189. [Google Scholar] [CrossRef]
- Firl, N.; Kienberger, H.; Rychlik, M. Validation of the sensitive and accurate quantitation of the fatty acid distribution in bovine milk. Int. Dairy J. 2014, 35, 139–144. [Google Scholar] [CrossRef]
- Deeth, H.C. Lipoprotein lipase and lipolysis in milk. Int. Dairy J. 2006, 16, 555–562. [Google Scholar] [CrossRef]
- Sordillo, L.M.; Contreras, G.A.; Aitken, S.L. Metabolic factors affecting the inflammatory response of periparturient dairy cows. Anim. Health Res. Rev. 2009, 10, 53–63. [Google Scholar] [CrossRef]
- Wang, X.; Kadarmideen, H.N. Metabolomics analyses in high-low feed efficient dairy cows reveal novel biochemical mechanisms and predictive biomarkers. Metabolites 2019, 9, 151. [Google Scholar] [CrossRef] [PubMed]
- Demarquoy, J.; Le Borgne, F. Crosstalk between mitochondria and peroxisomes. World J. Biol. Chem. 2015, 6, 301. [Google Scholar] [CrossRef] [PubMed]
- Schukken, Y.H.; Gunther, J.; Fitzpatrick, J.; Fontaine, M.C.; Goetze, L. Host-response patterns of intra mammary infections in dairy cows. Vet. Immunol. Immunopathol. 2011, 144, 270–289. [Google Scholar] [CrossRef]
- Yarabbi, H.; Mortazavi, A.; Mehraban, M.; Sepehri, N. Effect of somatic cells on the physic-chemical and microbial properties of raw milk in different seasons. Int. J. Plant Animal Env. Sci. 2014, 4, 289–298. [Google Scholar]
- Zenebe, N.; Habtamu, T.; Endale, B. Study on bovine mastitis and associated risk factors in Adigrat, Northern Ethiopia. Afr. J. Microbiol. Res. 2014, 8, 327–331. [Google Scholar]
- Jyothi, S.; Putty, K.; Narasimha Reddy, Y.; Pushpa, R.; Dhanalakshmi, K. Characterization of Staphylococcus sp isolates from milk of cross bred cows on the day of drying. Pharma Innov. 2018, 7, 500–502. [Google Scholar]
- Sahoo, S.S.; Sahoo, N.; Parida, G.S. Antibiogram of bacterial isolates from bovine subclinical mastitis. Indian Vet. J. 2009, 86, 1298–1299. [Google Scholar]
- Harini, H.; Sumathi, B.R. Screening of bovine milk samples for sub-clinical mastitis and antibiogram of bacterial isolates. Vet. World. 2011, 4, 358. [Google Scholar]
- Demissie, T.F.; Menghistu, H.T.; Mitiku, M.A. Prevalence of mastitis and identification of its bacterial causative agents in small holder dairy farms in and around Wukro of Tigray region, Ethiopia. Int. J. Adv. Res. Biol. Sci. 2018, 5, 10–22. [Google Scholar]
- Mekbib, B.; Furgasa, M.; Abunna, F.; Megersa, B.; Regassa, A. Bovine mastitis: Prevalence, risk factors and major pathogens in dairy farm of Holeta town Central Ethiopia. Ethiopia. J. Vet. World 2009, 3, 397–403. [Google Scholar] [CrossRef]
- Chandrasekaran, D.; Venkatesan, P.; Tirumurugaan, K.G.; Nambi, A.P.; Thirunavukkarasu, P.S.; Kumanan, K.; Ramesh, S. Pattern of antibiotic resistant mastitis in dairy cows. Vet. World. 2014, 7, 389–394. [Google Scholar] [CrossRef]
- Manasa, V.; Kumar, T.V.S.; Rao, T.P.; Kumar, K.A.; Sireesha, K. Incidence of bovine clinical mastitis caused by Escherichia coli. Int. J. Curr. Microbiol. Appl. Sci. 2019, 8, 1249–1256. [Google Scholar] [CrossRef]
- Hasan, M.T.; Islam, M.R.; Runa, N.S.; Uddin, A.H.M.M.; Singh, S.K. Study on bovine sub-clinical mastitis on farm condition with special emphasis on antibiogram of the causative bacteria. Bangladesh J. Vet. Med. 2016, 14, 161. [Google Scholar] [CrossRef]
- Singh, N.; Patel, R.; Singh, A.; Singh, P.; Patel, N. Isolation and Identification of Bacteria from Mastitis Effected Cattle and Antibiogram Study of Isolates. Environ. Ecol. 2016, 34, 2366–2369. [Google Scholar]
- Shaheen, S.; Bhat, B.A.; Allaie, A.A.; Gora, G.N. Antibiotic Resistance Profile of Milk Samples from Cattle Mastitis. Int. J. Curr. Microbiol. Appl. Sci. 2020, 9, 1299–1303. [Google Scholar] [CrossRef]
- Lalita, S.; Verma, A.K.; Amit, K.; Anu, R.; Rajesh, N. Incidence and pattern of antibiotic resistance of Staphylococcus aureus isolated from clinical and subclinical mastitis in cattle and buffaloes. Asian J. Anim. Sci. 2019, 9, 100–109. [Google Scholar]
- Maalik, A.; Shahzad, A.; Iftikhar, A.; Rizwan, M.; Ahmad, H.; Khan, I. Prevalence and antibiotic resistance of Staphylococcus aureus and risk factors for bovine subclinical mastitis in District Kasur, Punjab, Pakistan. Pak. J. Zool. 2019, 51, 1123. [Google Scholar] [CrossRef]
- Sadashiv, S.O.; Kaliwal, B.B. Prevalence of bovine mastitis in north Karnataka, India. Int. J. Pharm. Health Care Res. 2014, 1, 169–177. [Google Scholar]
- Idriss, S.E.; Foltys, V.; Tancin, V.; Kirchnerova, K.; Tancinova, D.; Zaujec, K. Mastitis pathogens and their resistance against antimicrobial agents in dairy cows in Nitra, Slovakia. Slovak J. Anim. Sci. 2014, 47, 33–38. [Google Scholar]
- Beyene, G.F. Antimicrobial susceptibility of Staphylococcus aureus in cow milk, Afar Ethiopia. Int. J. Modern Chem. Appl. Sci. 2016, 3, 280–283. [Google Scholar]
- Bhat, A.M.; Soodan, J.S.; Singh, R.; Dhobi, I.A.; Hussain, T.; Dar, M.Y.; Mir, M. Incidence of bovine clinical mastitis in Jammu region and antibiogram of isolated pathogens. Vet. World 2017, 10, 984. [Google Scholar] [CrossRef] [PubMed]
- Dereje, K.; Kebede, A.; Abebe, N.; Tamiru, Y. Isolation, identification and antimicrobial susceptibility test of mastitis causing bacteria at Holeta Agricultural Research Center Dairy Farms. Int. J. Anim. Sci. Technol. 2018, 2, 6–13. [Google Scholar] [CrossRef]
- National Mastitis Council (NMC). Microbiological Procedures for the Diagnosis of Udder Infection, 3rd ed.; National Mastitis Council Inc.: Arlington, VA, USA, 1990. [Google Scholar]
- Xia, J.; Mandal, R.; Sinelnikov, I.V.; Broadhurst, D.; Wishart, D.S. MetaboAnalyst 2.0—A comprehensive server for metabolomic data analysis. Nucleic Acids Res. 2012, 40, W127–W133. [Google Scholar] [CrossRef] [PubMed]

| Retention Time | Name | Molecular Formula | Molecular Weight (g/mol) | Area (%) |
|---|---|---|---|---|
| 19.670 | Tetradecanoic acid | C14H28O2 | 228.37 | 14.14 |
| 22.111 | n-Hexadecanoic acid | C16H32O2 | 256.42 | 56.06 |
| 7.082 | Hexanoic acid | C6H12O2 | 116.16 | 3.13 |
| 13.281 | n-Decanoic acid | C10H20O2 | 172.26 | 4.38 |
| 16.839 | Dodecanoic acid | C12H24O2 | 200.32 | 2.71 |
| 20.898 | Tricosanoic acid | C23H46O2 | 354.6 | 2.35 |
| 21.866 | cis-7-Hexadecenoic acid | C16H30O2 | 254.41 | 20.47 |
| 7.070 | Caprylic acid | C8H16O2 | 144.21 | 22.14 |
| 21.690 | 2-Hexadecenoic acid, methyl ester, (E)- | C17H32O2 | 268.4 | 12.58 |
| 19.249 | Methyl tetradecanoate | C15H30O2 | 242.4 | 15.90 |
| 23.321 | 1,2-Benzenedicarboxylic acid, bis (2-ethylhexyl) ester | C24H38O4 | 390.6 | 52.78 |
| 16.282 | Dodecanoic acid, methyl ester (Methyl laurate or Methyl dodecanoate) | C13H26O2 | 214.34 | 8.11 |
| 21.690 | Hexadecanoic acid, methyl ester or Methyl palmitate or Methyl hexadecanoate | C17H34O2 | 270.5 | 54.38 |
| 17.311 | Methyl stearate | C19H38O2 | 298.5 | 2.34 |
| 22.050 | Succinic acid, 2-ethylhexyl geranyl ester | C22H38O4 | 366.5 | 3.10 |
| 22.005 | Hexadecyl nonanoate or Cetyl nonanoate | C25H50O2 | 382.7 | 11.53 |
| 23.177 | Fumaric acid, dodecyl hex-4-yn-3-yl ester | C22H36O4 | 364.5 | 27.83 |
| Query | Match | HMDB | PubChem | KEGG | SMILES | Comment |
|---|---|---|---|---|---|---|
| Tetradecanoic acid | Myristic acid | 0000806 | 11005 | C06424 | CCCCCCCCCCCCCC(=O)O | 1 |
| n-Hexadecanoic acid | Palmitic acid | 0000220 | 985 | C00249 | CCCCCCCCCCCCCCCC(=O)O | 1 |
| Hexanoic acid | Caproic acid | 0000535 | 8892 | C01585 | CCCCCC(=O)O | 1 |
| n-Decanoic acid | Capric acid | 0000511 | 2969 | C01571 | CCCCCCCCCC(=O)O | 1 |
| Dodecanoic acid | Dodecanoic acid | 0000638 | 3893 | C02679 | CCCCCCCCCCCC(=O)O | 1 |
| Tricosanoic acid | Tricosanoic acid | 0001160 | 17085 | NA | CCCCCCCCCCCCCCCCCCCCCCC(=O)O | 1 |
| cis-7-Hexadecenoic acid | Hypogeic acid | 0002186 | 5318393 | NA | CCCCCCCC/C=C\CCCCCC(=O)O | 1 |
| Caprylic acid | Octanoic acid | 0000482 | 379 | C06423 | CCCCCCCC(=O)O | 1 |
| Methyl hexadecenoate | 2-Hexadecenoic acid, methyl ester, (E) | NA | NA | NA | NA | 0 |
| Methyl tetradecanoate | Methyl tetradecanoate | 0030469 | 31284 | NA | CCCCCCCCCCCCCC(=O)OC | 1 |
| Methyl dodecanoate | Methyl dodecanoate | 0031018 | 8139 | NA | CCCCCCCCCCCC(=O)OC | 1 |
| Methyl hexadecanoic acid | Methyl hexadecanoic acid | 0061859 | 8181 | C16995 | CCCCCCCCCCCCCCCC(=O)OC | 1 |
| Methyl stearate | Methyl stearate | 0034154 | 8201 | NA | CCCCCCCCCCCCCCCCCC(=O)OC | 1 |
| Succinic acid, 2-ethylhexyl geranyl ester | NA | NA | NA | NA | NA | 0 |
| 4,8,12,16-Octadecatetraen-1-ol, 4,9,13,17-tetramethyl | NA | NA | NA | NA | NA | 0 |
| Fumaric acid, dodecyl hex-4-yn-3-yl ester | NA | NA | NA | NA | NA | 0 |
| Total | Expected | Hits | Raw p | −log(p) | Holm Adjust | FDR | Impact | |
|---|---|---|---|---|---|---|---|---|
| Fatty acid biosynthesis | 47 | 0.21759 | 5 | 4.70 × 10−7 | 6.3281 | 3.95 × 10−5 | 3.95 × 10−5 | 0.0145 |
| Biosynthesis of unsaturated fatty acids | 36 | 0.16667 | 1 | 0.15551 | 0.80824 | 1 | 1 | 0 |
| Fatty acid elongation | 39 | 0.18056 | 1 | 0.16748 | 0.77605 | 1 | 1 | 0 |
| Fatty acid degradation | 39 | 0.18056 | 1 | 0.16748 | 0.77605 | 1 | 1 | 0.0204 |
| Total | Expected | Hits | Raw p | Holm p | FDR | |
|---|---|---|---|---|---|---|
| Epidermis | 216 | 2.6 | 5 | 0.0958 | 1 | 1 |
| Thyroid Gland | 12 | 0.145 | 1 | 0.136 | 1 | 1 |
| Prostate | 267 | 3.22 | 3 | 0.665 | 1 | 1 |
| Bladder | 87 | 1.05 | 1 | 0.668 | 1 | 1 |
| Platelet | 108 | 1.3 | 1 | 0.75 | 1 | 1 |
| Skeletal Muscle | 123 | 1.48 | 1 | 0.796 | 1 | 1 |
| Kidney | 164 | 1.98 | 1 | 0.886 | 1 | 1 |
| Spleen | 170 | 2.05 | 1 | 0.896 | 1 | 1 |
| Fibroblasts | 183 | 2.2 | 1 | 0.914 | 1 | 1 |
| Liver | 234 | 2.82 | 1 | 0.961 | 1 | 1 |
| Name | Mean (SD) of 0 (Healthy) | Mean (SD) of 1 (Subclinical) | p-Value | Fold Change | 0/1 | p Value Origin |
|---|---|---|---|---|---|---|
| Fat | 3.954 (0.828) | 3.353 (0.858) | 0.0411 (W) | 1.18 | Up | 0.0411 |
| Protein | 3.517 (0.466) | 3.057 (0.346) | 0.0002 (W) | 1.15 | Up | 0.0002 |
| Lactose | 4.226 (0.183) | 3.909 (0.540) | 0.0082 (W) | 1.08 | Up | 0.0082 |
| SNF | 7.532 (0.430) | 7.455 (0.653) | 0.4549 (W) | 1.01 | Up | 0.45488 |
| Specific Density | 25.835 (0.983) | 24.852 (4.394) | 0.0424 (W) | 1.04 | Up | 0.04235 |
| EC | 3.382 (0.213) | 3.913 (0.361) | <0.0001 (W) | −1.16 | Down | 0 |
| pH | 6.282 (0.404) | 6.848 (0.165) | <0.0001 (W) | −1.09 | Down | 0 |
| Bacteria | Total | No. of Pathogens Isolated | Prevalence % |
|---|---|---|---|
| Staphylococcus aureus | 90 | 54 | 60 |
| E. coli | 30 | 33.33 | |
| Mixed infections | 6 | 6.67 |
| Isolate | Antibiotics | Sensitive | Intermediate | Resistant |
|---|---|---|---|---|
| S. aureus | Doxycycline hydrochloride | 36 (66.6) | 10 (18.51) | 8 (14.81) |
| Gentamicin | 43 (79.6) | 8 (14.81) | 3 (5.55) | |
| Ciprofloxacin | 13 (24.07) | 8 (14.81) | 33 (61.11) | |
| Cefpodoxime | 6 (11.11) | 10 (18.51) | 38 (70.37) | |
| Tetracycline | 33 (61.11) | 9 (16.66) | 12 (22.22) | |
| Ofloxacin | 7 (12.96) | 10 (18.51) | 37 (68.51) | |
| Penicillin-G | - | - | 54 (100) | |
| E. coli | Doxycycline hydrochloride | 24 (80%) | 3 (10%) | 3 (10%) |
| Gentamicin | 21 (70%) | 5 (16.66%) | 4 (13.33%) | |
| Ciprofloxacin | 23 (76.6%) | 4 (13.33%) | 3 (10%) | |
| Cefpodoxime | 5 (16.66%) | 3 (10%) | 22 (73.33%) | |
| Tetracycline | 16 (53.33%) | 8 (26.66%) | 6 (20%) | |
| Ofloxacin | 15 (50%) | 7(23.33%) | 8 (26.66%) | |
| Penicillin-G | - | - | 30 (100%) |
| Group of Animals | Ganderbal |
|---|---|
| Healthy | 25 |
| Sub-clinical mastitis | 110 |
| Total | 135 |
| S. No | Antibiotic | Concentration |
|---|---|---|
| 1 | Doxycycline hydrochloride (DO) | 30 µg |
| 2 | Gentamicin (GEN) | 10 µg |
| 3 | Ciprofloxacin (CIP) | 5 µg |
| 4 | Cefpodoxime (CPD) | 10 µg |
| 5 | Tetracycline (TE) | 30 µg |
| 6 | Ofloxacin (OF) | 5 µg |
| 7 | Penicillin-G (P) | 10 units |
Publisher’s Note: MDPI stays neutral with regard to jurisdictional claims in published maps and institutional affiliations. |
© 2022 by the authors. Licensee MDPI, Basel, Switzerland. This article is an open access article distributed under the terms and conditions of the Creative Commons Attribution (CC BY) license (https://creativecommons.org/licenses/by/4.0/).
Share and Cite
Ali, A.; Mir, M.U.R.; Ganie, S.A.; Mushtaq, S.; Bukhari, S.I.; Alshehri, S.; Rashid, S.M.; Mir, T.M.; Rehman, M.U. Milk-Compositional Study of Metabolites and Pathogens in the Milk of Bovine Animals Affected with Subclinical Mastitis. Molecules 2022, 27, 8631. https://doi.org/10.3390/molecules27238631
Ali A, Mir MUR, Ganie SA, Mushtaq S, Bukhari SI, Alshehri S, Rashid SM, Mir TM, Rehman MU. Milk-Compositional Study of Metabolites and Pathogens in the Milk of Bovine Animals Affected with Subclinical Mastitis. Molecules. 2022; 27(23):8631. https://doi.org/10.3390/molecules27238631
Chicago/Turabian StyleAli, Aarif, Manzoor Ur Rahman Mir, Showkat Ahmad Ganie, Saima Mushtaq, Sarah I. Bukhari, Sultan Alshehri, Shahzada Mudasir Rashid, Tahir Maqbool Mir, and Muneeb U. Rehman. 2022. "Milk-Compositional Study of Metabolites and Pathogens in the Milk of Bovine Animals Affected with Subclinical Mastitis" Molecules 27, no. 23: 8631. https://doi.org/10.3390/molecules27238631
APA StyleAli, A., Mir, M. U. R., Ganie, S. A., Mushtaq, S., Bukhari, S. I., Alshehri, S., Rashid, S. M., Mir, T. M., & Rehman, M. U. (2022). Milk-Compositional Study of Metabolites and Pathogens in the Milk of Bovine Animals Affected with Subclinical Mastitis. Molecules, 27(23), 8631. https://doi.org/10.3390/molecules27238631

